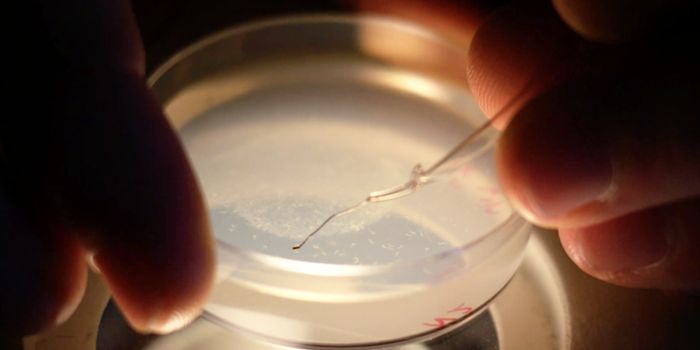
Muscle Cells Revealed Contracting at the Subcellular Level
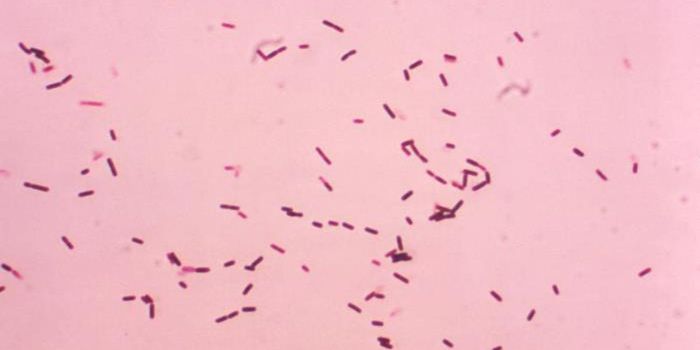
ATP & GTP Are Common in Biology - But What About CTP?

Biochemistry and molecular biology
Biochemistry and molecular biology are complementary fields of science involved with biology, the study of living organisms. Biochemistry focuses on the chemical processes which occur in living organisms. Molecular biology concentrates on how molecules within living organisms interact.
-
AUG 31, 2021Genetics & GenomicsGenetically modified mice, fruit flies, and zebrafish are commonly used in research. Scientists have now developed a met ...Written By: Carmen LeitchAUG 27, 2021Health & MedicineSince their discovery, there has been an interest in how ABO blood groups and infectious diseases may be related. In add ...Written By: Christopher DiMaioAUG 25, 2021Cell & Molecular BiologyScientists have used a tool called cryo-electron microscopy to get an unprecedented and detailed look at infectious, mis ...Written By: Carmen LeitchAUG 24, 2021MicrobiologyResearch has indicated that babies get many benefits from breastmilk, even if they are only fed that way for a very shor ...Written By: Carmen LeitchAUG 24, 2021Genetics & GenomicsSome rare genetic disorders impair a critical molecule that has to be replaced, or serious disease or disability will oc ...Written By: Carmen LeitchAUG 22, 2021Genetics & GenomicsOne of the most difficult aspects of gene therapy might be ensuring that it gets into the right cells safely so it can h ...Written By: Carmen LeitchAUG 21, 2021MicrobiologyResearchers investigating how the SARS-CoV-2 virus gets into cells to cause COVID-19 learned early on in the pandemic th ...Written By: Carmen LeitchAUG 19, 2021Clinical & Molecular DXCancerous tissues can be difficult to spot, particularly at the early stages. The malignant cells are sometimes indistin ...Written By: Tara FernandesAUG 18, 2021Cell & Molecular BiologyFor many years, researchers have studied how an enzyme called APOBEC3 can help protect the body from pathogenic viruses, ...Written By: Carmen LeitchAUG 17, 2021Genetics & GenomicsThe human body develops from one fertilized cell, and in some way, all of our cells are derived from that first one. But ...Written By: Carmen LeitchAUG 15, 2021Plants & AnimalsThe exotic Venus flytrap is a famous carnivorous plant that's easy to identify. But it seems that another carnivorous pl ...Written By: Carmen LeitchAUG 11, 2021Genetics & GenomicsOver 70,000 around the world have cystic fibrosis (CF), one of the world's most common genetic diseases. People with ...Written By: Carmen LeitchAUG 09, 2021Cell & Molecular BiologyMuscle cells were once thought to be the smallest units that experienced contraction. But new research has suggested tha ...Written By: Carmen LeitchAUG 06, 2021Genetics & GenomicsGene editing has advanced in many ways over the past few decades. Most methods in genetic engineering involve altering t ...Written By: Carmen LeitchAUG 04, 2021Cell & Molecular BiologyBoth processed and prepared foods often contain high levels of sugar. It's thought that the average American eats almost ...Written By: Carmen LeitchAUG 03, 2021Genetics & GenomicsWhen a gene is active, it's transcribed from DNA to RNA, and a specific sequence in the genetic code acts like a sig ...Written By: Carmen LeitchAUG 02, 2021Cell & Molecular BiologyTo understand cellular processes, scientists have to study proteins, which play critical roles in virtually every aspect ...Written By: Carmen LeitchAUG 01, 2021Genetics & GenomicsThroughout our lives, new cells often replace the ones that become damaged or worn out. As cells divide, they have to re ...Written By: Carmen LeitchAUG 01, 2021Cell & Molecular BiologyUbiquitin is a crucial, small protein that is thought to be present in all eukaryotic cells and is very similar from one ...Written By: Carmen LeitchJUL 28, 2021MicrobiologyHistones are proteins that are used to organize and compact DNA. Some giant viruses called Marseilleviridae have also be ...Written By: Carmen LeitchJUL 26, 2021Cell & Molecular BiologyThere are natural detergents that cells can use to defend themselves from pathogens. Scientists have now identified a pr ...Written By: Carmen LeitchJUL 25, 2021Genetics & GenomicsParkinson's disease is a complex neurodegenerative disorder. While age is a major risk factor, genetics and environmenta ...Written By: Carmen LeitchJUL 21, 2021Genetics & GenomicsScientists have shown that it's possible to assess what organisms might be living in a particular habitat by collecting ...Written By: Carmen LeitchJUL 19, 2021Cell & Molecular BiologyAdenosine triphosphate (ATP) is a molecule that provides crucial energy to activate a wide array of biological processes ...Written By: Carmen Leitch
AUG 31, 2021
Genetics & Genomics
Genetically modified mice, fruit flies, and zebrafish are commonly used in research. Scientists have now developed a met
...
Written By:
Carmen Leitch
AUG 27, 2021
Health & Medicine
Since their discovery, there has been an interest in how ABO blood groups and infectious diseases may be related. In add
...
Written By:
Christopher DiMaio
AUG 25, 2021
Cell & Molecular Biology
Scientists have used a tool called cryo-electron microscopy to get an unprecedented and detailed look at infectious, mis
...
Written By:
Carmen Leitch
AUG 24, 2021
Microbiology
Research has indicated that babies get many benefits from breastmilk, even if they are only fed that way for a very shor
...
Written By:
Carmen Leitch
AUG 24, 2021
Genetics & Genomics
Some rare genetic disorders impair a critical molecule that has to be replaced, or serious disease or disability will oc
...
Written By:
Carmen Leitch
AUG 22, 2021
Genetics & Genomics
One of the most difficult aspects of gene therapy might be ensuring that it gets into the right cells safely so it can h
...
Written By:
Carmen Leitch
AUG 21, 2021
Microbiology
Researchers investigating how the SARS-CoV-2 virus gets into cells to cause COVID-19 learned early on in the pandemic th
...
Written By:
Carmen Leitch
AUG 19, 2021
Clinical & Molecular DX
Cancerous tissues can be difficult to spot, particularly at the early stages. The malignant cells are sometimes indistin
...
Written By:
Tara Fernandes
AUG 18, 2021
Cell & Molecular Biology
For many years, researchers have studied how an enzyme called APOBEC3 can help protect the body from pathogenic viruses,
...
Written By:
Carmen Leitch
AUG 17, 2021
Genetics & Genomics
The human body develops from one fertilized cell, and in some way, all of our cells are derived from that first one. But
...
Written By:
Carmen Leitch
AUG 15, 2021
Plants & Animals
The exotic Venus flytrap is a famous carnivorous plant that's easy to identify. But it seems that another carnivorous pl
...
Written By:
Carmen Leitch
AUG 11, 2021
Genetics & Genomics
Over 70,000 around the world have cystic fibrosis (CF), one of the world's most common genetic diseases. People with
...
Written By:
Carmen Leitch
AUG 09, 2021
Cell & Molecular Biology
Muscle cells were once thought to be the smallest units that experienced contraction. But new research has suggested tha
...
Written By:
Carmen Leitch
AUG 06, 2021
Genetics & Genomics
Gene editing has advanced in many ways over the past few decades. Most methods in genetic engineering involve altering t
...
Written By:
Carmen Leitch
AUG 04, 2021
Cell & Molecular Biology
Both processed and prepared foods often contain high levels of sugar. It's thought that the average American eats almost
...
Written By:
Carmen Leitch
AUG 03, 2021
Genetics & Genomics
When a gene is active, it's transcribed from DNA to RNA, and a specific sequence in the genetic code acts like a sig
...
Written By:
Carmen Leitch
AUG 02, 2021
Cell & Molecular Biology
To understand cellular processes, scientists have to study proteins, which play critical roles in virtually every aspect
...
Written By:
Carmen Leitch
AUG 01, 2021
Genetics & Genomics
Throughout our lives, new cells often replace the ones that become damaged or worn out. As cells divide, they have to re
...
Written By:
Carmen Leitch
AUG 01, 2021
Cell & Molecular Biology
Ubiquitin is a crucial, small protein that is thought to be present in all eukaryotic cells and is very similar from one
...
Written By:
Carmen Leitch
JUL 28, 2021
Microbiology
Histones are proteins that are used to organize and compact DNA. Some giant viruses called Marseilleviridae have also be
...
Written By:
Carmen Leitch
JUL 26, 2021
Cell & Molecular Biology
There are natural detergents that cells can use to defend themselves from pathogens. Scientists have now identified a pr
...
Written By:
Carmen Leitch
JUL 25, 2021
Genetics & Genomics
Parkinson's disease is a complex neurodegenerative disorder. While age is a major risk factor, genetics and environmenta
...
Written By:
Carmen Leitch
JUL 21, 2021
Genetics & Genomics
Scientists have shown that it's possible to assess what organisms might be living in a particular habitat by collecting
...
Written By:
Carmen Leitch
JUL 19, 2021
Cell & Molecular Biology
Adenosine triphosphate (ATP) is a molecule that provides crucial energy to activate a wide array of biological processes
...
Written By:
Carmen Leitch